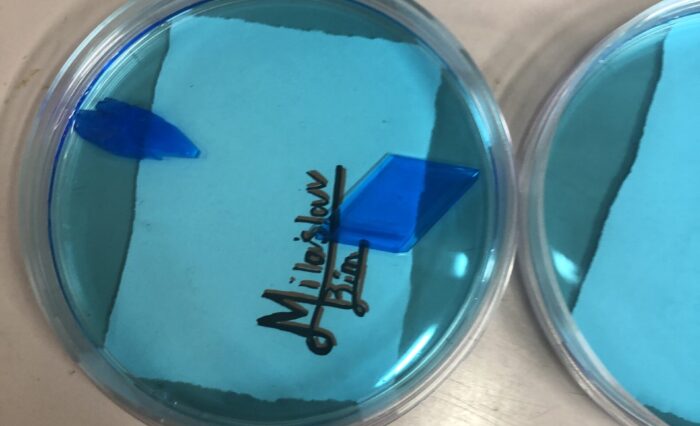
úvodní foto

Aktuální informace
Zobrazit všechny příspěvkyKonferenční finále Jr. NBA v basketbale
Ve čtvrtek 20. 11. se ve Žďáře nad Sázavou odehrálo konferenční finále Jr. NBA. V prvním zápase jsme se měli utkat s týmem z Olomouce, ale soupeř nakonec vůbec nepřijel. Rovnou jsme tak postoupili do semifinále. V tom jsme narazili na tým z Brandýsa nad Labem. V základním kole jsme s nimi jednou vyhráli a jednou prohráli. Bohužel semifinále se nám […]
Školní družina v pekle Čertovina
Děti ze III.oddělení se vydaly na výlet do Pekla Čertovina, kde děti nakoukly k samotnému Luciferovi a prošly si čertovskou školou. Všechny pekelné zkoušky zvládly na jedničku. Výlet byl plný zábavy i malých pekelných zážitků.
6.A v Nízkoprahovém centu
Navštívili jsme nymburský N KLUB, kde nám Tereza, Kristýna a Dominika ukázali prostor určený zadarmo pro všechny děti, mladistvé i mladé dospělé a přestavili program, který zde organizují. Pak se šesťáci rozdělili do skupinek a z vylosovaných slov vymýšleli nápadité, a mnohdy vtipné, příběhy. Následovala volná zábava, a tak se děti rozběhly do všech koutů centra. Někdo […]
Tradiční zeměpisný program pro sedmáky
Již mnoho let se žáci sedmých tříd účastní zeměpisných programů v nymburském kině. Letos jsme se na hodinu přesunuli do Ekvádoru. Programem „Ekvádor – po stopách evoluce“ nás provedl přímo jeden z účastníků výpravy. Pomocí krásných animací jsme se seznámili se stručnou historií území dnešního Ekvádoru. Následná videa a fotografie ze současnosti prokládal, moderátor a […]
VÝTVARKA V LISTÍ
Listopadové počasí bývá už chladnější, letos ale teploty lámaly rekordy, a tak jsme jednu hodinu VV trávili venku v listí. Úkolem bylo prostorové zobrazení nějakého zvířete, což se všem povedlo. Však se podívejte …… Konec hodiny byl pak ve znamení „koulování“ :o))
Nový sChOOL
Nová redakce pro vás připravila v rámci předmětu DÍLNY ČTENÍ A PSANÍ nové číslo školního časopisu. Navázala na práci předchozích redakcí, a i když jsou všichni nováčci, odvedli dobrou práci. Věříme, že si čtení časopisu užijete a budete nás podporovat i v budoucnu. Alena Danzerová
Jak 7.B a 7.C jela „lovit“ ryby ….
….. no lovit úplně tedy ne, spíš jsme lovili informace o různých rybách, a to ať už o mořských tak i o sladkovodních. Exkurze proběhla v komplexu akvárií – v Mořském světe v Praze Holešovicích. Měli jsme štěstí, protože akvária byla velmi rozmanitá a vidět bylo velké množství různých druhů. Kromě ryb byli k vidění i zástupci korýšů a […]
PŘÍBĚH VÁNOČNÍHO STROMEČKU NA ZÁMKU LOUČEŇ
Letos poprvé žáci předmětu PVP Výtvarné techniky vyjeli na tvořivou exkurzi na zámek Loučeň. Před prohlídkou zámku se prošli největším zámeckým labyrintem, pak následovala komentovaná prohlídka zámku – k vidění bylo velké množství různě ozdobených vánočních stromečků. Hlavním bodem bylo zdobení skleněné ozdoby v dílničce pro zámkem. Každý si vytvořil svou krásnou ozdobu technikou posypu třpytkami. Během […]
VYROSTE NEBO NEVYROSTE ….
…. to je to, o co tu teď jde! Deváťáci si v rámci výuky PŘ vyzkoušeli namíchat ten správný roztok, aby se jim vytvořily co největší krystaly. Co se týče rychlosti, tak vítězové jsou v 9.C – tam se první krystalky objevily už druhý den. Velikostně ale vítězí 9.A. Tady si krystalizace dala na čas. […]
Savci ZOO Praha
Přírodopis v osmém ročníku patří mezi ty nejoblíbenější, protože je věnován savcům. Exkurze do ZOO se tedy sama nabízela. Účastnili se jí všechny děti osmých ročníků a byl to moc prima školní den. Celé dopoledne probíhalo v prostředí ZOO, kde děti pozorovaly různé druhy savců a vyplňovali pracovní list se zvědavými otázkami právě na savce v pražské ZOO. […]
Výběr fotografií ze života školy